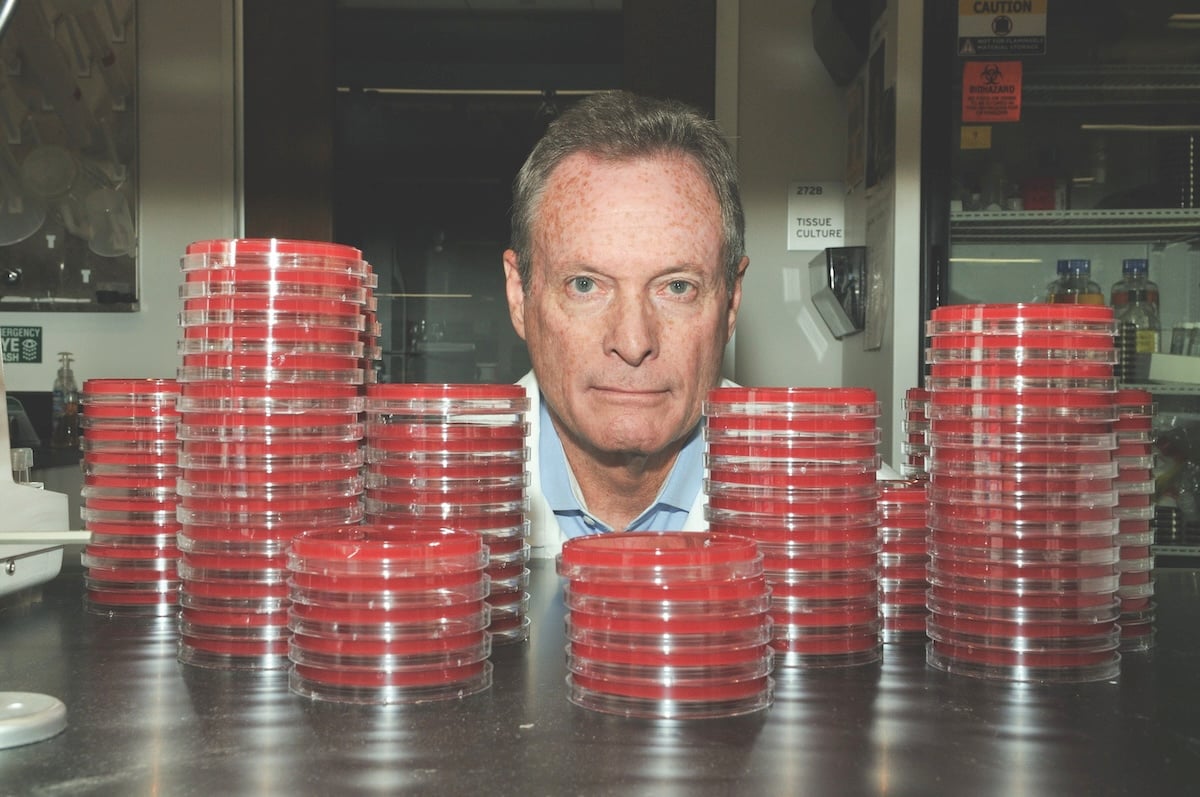

Since its founding 74 years ago, the Lundquist Institute for Biomedical Innovation at Harbor-UCLA Medical Center in West Carson has become a major – if sometimes overlooked – research hub and economic engine for the South Bay and the entire county.
Through its partnerships with the neighboring Harbor-UCLA Medical Center, UCLA Health and more recently, the onsite BioLabs incubator, the institute has developed a “bedside to lab bench to bedside again” approach to biomedical research that has distinguished it from most other local bioscience research institutes.
But over that past year, that pipeline of therapeutic development has been severely tested by funding cutbacks from Washington D.C., forcing institute executives and researchers to scramble for other funding sources to keep their projects alive.
“It started exactly one year ago, the very same month I started in my post here,” said Joe Ramos, a longtime cancer researcher and top-level cancer center executive who assumed the chief executive post at the Lundquist Institute in February of last year.
 Joe Ramos is president and chief executive of the Lundquist Institute.
Joe Ramos is president and chief executive of the Lundquist Institute.
(Photo by Thomas Wasper)
That month, officials within President Donald Trump’s second administration announced their intention to revamp a funding formula for National Institutes of Health grants, with results that could have stalled research in its tracks. The Lundquist Institute receives tens of millions of dollars annually in NIH grants – nearly $70 million in 2024.
The formula change would have subtracted out overhead and other indirect research costs from grant awards, effectively cutting the amount of each grant anywhere between 30% and 40%.
“Fortunately, Congress stepped up and that didn’t happen,” Ramos said.
But over the next several months, increasing numbers of NIH grant applications nationwide were either delayed or rejected outright, with the stated reason that the research projects didn’t align with the goals of the Trump administration.
Ramos said this has hit research projects involving population studies particularly hard. “We have some projects like that, but not as high a percentage as at other research centers,” he said.
Nonetheless, some research projects at the institute have been delayed.
One researcher at the institute, Michael Yeaman, who leads a team looking into ways to prevent viruses and bacteria from developing resistance to antibiotics and other drug therapies, said some of his team’s grant applications have been caught up in the political situation.
“The existing grants we have on hand have not been affected so far,” Yeaman said. “But we have submitted some grant (applications) for review that have included vaccine studies and a handful of those have been affected. They have either not been reviewed at all or they have not been favorably scored.”
Yeaman, who is a senior investigator and a director of the Institute for Infection & Immunity at the Lundquist Institute, said there seems to be an increased reluctance at the NIH to consider grants that aim to develop novel vaccines.
“The environment has changed,” he said.
Another Lundquist investigator who has been caught up in the funding morass at the National Institutes of Health is Denise Al Alam. Much of her research focuses on therapies for lung diseases in premature babies.
“We’ve had one federal grant delayed and as a result, we are more hesitant to submit grants to the NIH going forward,” Alam said.
 Denise Al Alam studying
Denise Al Alam studying
a magnification of lung tissue. (Photo by Thomas Wasper)
On top of all this, there was the government shutdown last fall, which Ramos said halted all grant activity for that six-week span.
“Things are only getting back into gear now,” Ramos said late last month.
Yeaman added that if his team’s grant applications and thousands of other grant applications submitted nationwide are ultimately not approved, it could create gaps in the research pipeline to bring new drugs to market – unless other funding sources step up.
To this end, Yeaman said his team is looking at ways to make the grant applications more in line with the announced priorities of the NIH, such as refocusing the grant wording to focus on chronic diseases.
“We are also looking at retooling some of the grants and sending them to private foundations,” such as the Gates Foundation, he said.
Other researchers have also become more creative in going after other funding sources.
Lynda Polgreen, clinical director of the Center for Treatment of Rare Disease at the Lundquist Institute, has chosen to strengthen ties with patient advocacy groups, particularly regarding work her team is doing with cannabidiol therapy.
“This area has always been tough to get federal funds for, not just today,” she said. “Patient advocacy groups are stepping up to raise more funds when the feds don’t approve the grant funding.”
Polgreen’s team also applied for and received last fall a $9 million grant from the California Institute for Regenerative Medicine, or CIRM. That institute was established in 2004 following voter approval of a $3 billion bond measure for stem cell research. Voters approved another $5 billion in bond funding for CIRM in 2020.
The grant to the team co-led by Polgreen authorizes the establishment of an institute within the Lundquist Institute that focuses on stem cell research. It also funds the training of health care professionals to spur patients in communities around the Lundquist Institute to sign up for clinical trials involving stem cell therapies.
Alam said her team is also now more reliant on CIRM funding and added that her team is more aggressively going after funding from foundations and other philanthropic sources.
History of innovation
Keeping research projects funded is just the latest challenge for the Lundquist Institute, which was founded in 1952 by a group of physicians at what was then known as Harbor General Hospital. The previous year, the hospital had affiliated with UCLA to become a teaching and research hospital, which resulted in a need for research and lab space close to the hospital. The nonprofit these physicians founded soon took the name Research and Education Institute.
In those early years, the institute had both research and training programs. Among the breakthroughs on the research side were the first widely used cholesterol test and honing of artificial fertilization techniques.
The institute also distinguished itself on the training side. In the late 1960s, a physician named John Criley launched a program to train Los Angeles County firefighters on how to treat patients at the site of injury, stabilizing them for transport to the nearest hospital. This was among one of the first paramedic models in emergency medical care. Indeed, according to Lundquist Institute lore, the term “paramedic” was coined as a part of this course. That claim has some competition as the term paramedic was in use around the same time at the Freedom House Ambulance Service in Pittsburgh.
The Research and Education Institute followed that up with the opening in 1970 of the Women’s Health Care Clinic that established what it claims was the nation’s first nurse practitioner training program.
Michael Yeaman is an investigator of infectious diseases. (Photo by Thomas Wasper)
Michael Yeaman is an investigator of infectious diseases. (Photo by Thomas Wasper)
Over the next 30 years, a steady stream of medical research breakthroughs occurred at the institute. These included synthetic lung surfactant therapies that enabled premature infants with underdeveloped lungs to breathe and survive and an enzyme replacement therapy for mucopolysaccharidosis type 1 – also known as Hurler Syndrome – a devastating disease where the body lacks a key enzyme to break down sugars.
In 2003, the Research and Education Institute was renamed the Los Angeles Biomedical Research Institute, or LA BioMed, to mark the steady expansion in scope at the institute.
Another more dramatic transformation took place in 2019. First, it was the opening of a new 78,000-square-foot medical research building featuring wet and dry lab space. That building is the newest and largest on the 11.4-acre institute campus. There are eight other buildings with lab space and 11 bungalows, dating back to the middle of the last century.
Shortly after the building was completed, Cambridge, Massachusetts-based biotechnology incubator operator BioLabs opened an 18,000-square-foot incubator that takes up an entire floor of the building. That incubator now holds 40 companies all seeking to bring new biotech therapies and devices to market.
To cap off that remarkable year, prominent Southern California philanthropists Melanie and Richard Lundquist donated $70 million to the institute – the largest single donation in its history – resulting in its renaming as the Lundquist Institute for Biomedical Innovation. Richard Lundquist is the principal owner of El Segundo-based real estate development firm Continental Development Corp.
The opening of the BioLabs incubator reinforced the notion of the “bedside-to-bench-to-bedside again” approach at the institute.
Physician-researchers practicing at Harbor-UCLA hospital look at ways to treat seemingly intractable conditions among their patients, tinker with possible solutions in the lab space at the institute, further develop their therapies and devices at an affiliated biomedical and biotech incubator on the premises, then bring those treatments to patients at the hospital and elsewhere.
“That model has produced meaningful translational impact over decades,” said Stephanie Hsieh, chief executive of BioScience L.A., an industry catalyst organization.
Most bioscience research institutes are either part of academic institutions or entirely within hospitals. Even though the Lundquist Institute has affiliations with both, it is independently run and governed.
“We can be more agile that a major university research program, where everything has to get the approval of the university’s board,” Ramos said.
Hsieh said she sees the transformed Lundquist Institute as an example for the rest of the region.
“I use them as a poster child of what we need more of,” Hsieh said. “It’s the way they pull pieces together to create an innovation hub.”
She described the institute as a microcosm.
“It’s a start-up community with a crown jewel research institute and also a hospital that provides the bedside piece,” she said. “There really isn’t anything else like it in the region.”
In the near term, the Lundquist Institute is planning upgrades to bolster support for clinical trials, according to Kevin Wong, the institute’s chief financial officer.
For the longer term, the institute has a bold plan: creating a biotech park on 15 acres of adjacent space where companies that outgrow their space at the BioLabs incubator but aren’t yet big enough to require 20,000 square feet or more of their own space can locate for several years.
 The Lundquist Institute for Biomedical Innovation in West Carson. (Photo by Thomas Wasper)
The Lundquist Institute for Biomedical Innovation in West Carson. (Photo by Thomas Wasper)
“We call it graduation space for these companies,” Ramos said.
He added the institute is working with the County of Los Angeles and commercial real estate developer Trammell Crow Co., a subsidiary of Dallas-based CBRE Group Inc. on the design and parameters of this planned bioscience tech park.
“This is all part of our long-term plan to create a true biomedical ecosystem here,” Ramos said. “We’ve had all or most of the elements here for some time, but we’re really working to link them up and connect them better.
“We’re growing the partnership with the hospital, and we’re intensifying our work on the preclinical research that’s always gone on here,” he added. “Then, we have BioLabs to develop the tech, and now we’re working on developing that space for companies at BioLabs to graduate into … so, you can really see how it all clicks together.”

